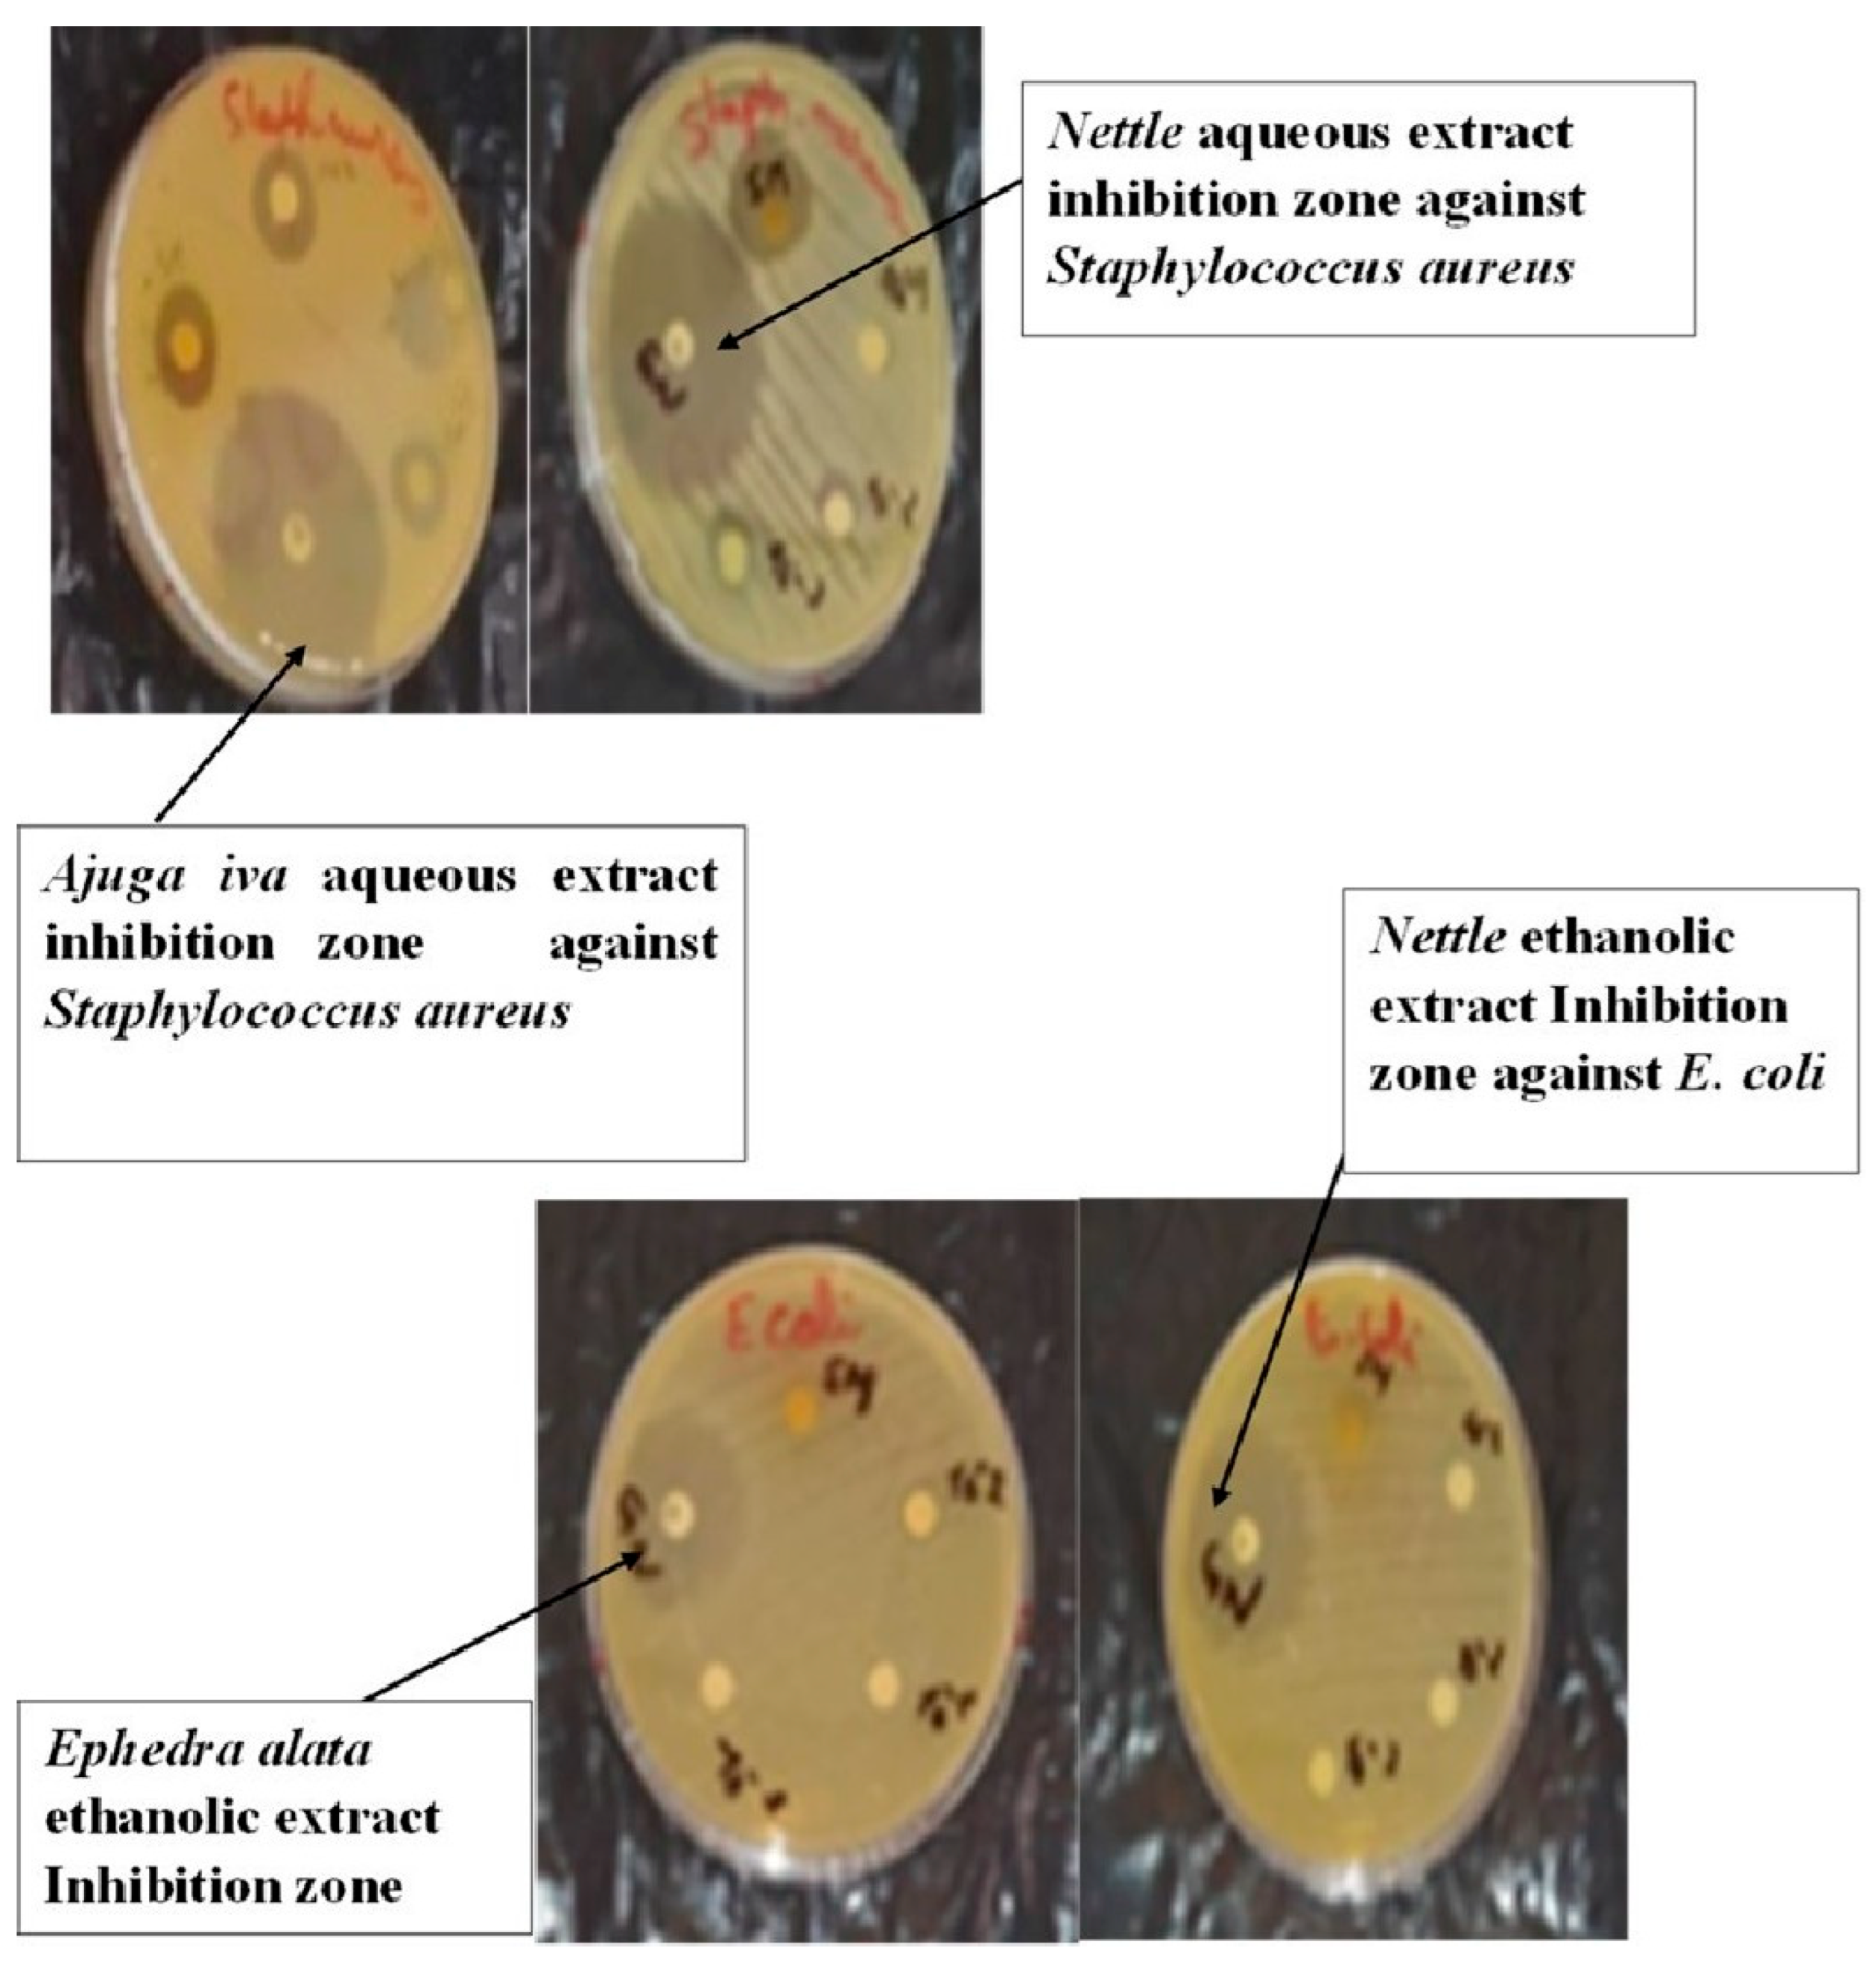
Microbiolres 16 00108 g004

Comparison of Antioxidant and Antibacterial Properties of Five Plants with Anti-Diabetes and Anti-Cancer Potential
Abstract
1. Introduction
2. Materials and Methods
2.1. Plants
2.2. Reagents
2.3. Extraction Process
2.3.1. Extraction with Ethanol Maceration
2.3.2. Extraction Using Decoction
2.4. Characterization
2.4.1. Fourier Transform Infrared Analysis FTIR
2.4.2. Determination of Total Polyphenols
2.4.3. Dosage of Flavonoids
2.4.4. Evaluation of Antibacterial Activity
2.5. Statistical Analysis
3. Results and Discussion
3.1. Extraction Yield
3.2. Total Phenolic Content
3.3. Total Flavonoid Content
3.4. Antibacterial Analysis
3.5. FTIR Analysis
4. Conclusions
Author Contributions
Funding
Institutional Review Board Statement
Informed Consent Statement
Data Availability Statement
Acknowledgments
Conflicts of Interest
Abbreviations
| m/v | Mass of the plant/volume of the extraction solvent |
| MAE | Microwave-Assisted Extraction |
| UAE | Ultrasonically Assisted Extraction |
| mg EGA/g DE | mg equivalent of gallic acid per gram of dry extract |
| mg EQ/g DE | mg equivalent of quercetin per gram of dry extract |
| PPT | Total polyphenols |
| E coli | Escherichia coli |
References
- Farnsworth, N.R.; Akerele, O.; Bingel, A.S.; Soejarto, D.D.; Guo, Z. Medicinal plants in therapy. Bull. World Health Organ. 1985, 63, 965–981. Available online: https://pmc.ncbi.nlm.nih.gov/articles/PMC2536466/ (accessed on 15 July 2023). [CrossRef] [PubMed]
- Khitri, W.; Lachgueur, N.; Tasfaout, A.; Lardjam, A.; Khalfa, A. Antilithiasic plants used in traditional medicine in Oran, Algeria: Ethnobotanical survey and phytochemical screening. J. Ethnoecol. 2016, 9, 2267–2419. [Google Scholar] [CrossRef]
- Quieda, F. Médecine Arabe et Ethnopharmacologie, les Plantes du Coran; CNRSL Beyrouth, Ed.; Faculty de Pharmacy, Libaneese University: Liban, 2006; Available online: https://books.openedition.org/irdeditions/7247?lang=fr (accessed on 1 June 2023).
- Mbaïhougadobé, S.; Ngakegni-Limbili, A.C.; Gouollaly, T.; Koane, J.N.; Ngaïssona, P.; Loumpangou, C.N.; Mahmout, Y.; Ouamba, J.-M. Evaluation de l’activité anti-oxydante de trois espèces de plantes utilisées dans le traitement de la goutte au Tchad. Rev. CAMES—Série Pharm. Méd. Trad. Afr. 2017, 18, 28–35. Available online: https://asjp.cerist.dz/en/article/43129 (accessed on 1 March 2023).
- Ziyyat, A.; Legssyer, A.; Mekhfi, H.; Dassouli, A.; Serhrouchni, M.; Benjelloun, W. Phytotherapy of hypertension and diabetes in oriental Moroccan. J. Ethnopharmacol. 1997, 58, 45–54. [Google Scholar] [CrossRef]
- Accipe, L.; Abadie, A.; Neviere, R.; Bercion, S. Antioxidant Activities of Natural Compounds from Caribbean Plants to Enhance Diabetic Wound Healing. Antioxidants 2023, 12, 1079. [Google Scholar] [CrossRef] [PubMed]
- Allali, H.; Benmehdi, H.; Dib, M.A.; Tabti, B.; Ghalem, S.; Benabadji, N. Phytotherapy of Diabetes in West Algeria. Asian J. Chem. 2008, 20, 2701–2710. Available online: https://pdfs.semanticscholar.org/f67c/f41460e6e416c153fbb0934f0fba99aa9266.pdf (accessed on 1 June 2024).
- Ghasemzadeh, A.; Jaafar, H.Z.E.; Rahmat, A. Elevated Carbon Dioxide Increases Contents of Flavonoids and Phenolic Compounds, and Antioxidant Activities in Malaysian Young Ginger (Zingiber officinale Roscoe) Varieties. Molecules 2010, 15, 7907–7922. [Google Scholar] [CrossRef] [PubMed]
- Ilkhanizadeh1, B.; Shirpoor, A.; Khadem Ansari, M.H.; Nemati, S.; Rasmi, Y. Protective Effects of Ginger (Zingiber officinale) Extractagainst Diabetes-Induced Heart Abnormality in Rats. Diabetes Metab. J. 2016, 40, 46–53. [Google Scholar] [CrossRef]
- Grzanna, R.; Lindmark, L.; Frondoza, C.G. Ginger an herbal medicinal product with broad anti-inflammatory actions. J. Med. Food 2005, 8, 125–132. [Google Scholar] [CrossRef]
- Zaman, S.; Mirje, M.M.; Ramabhimaiah, S. Evaluation of the Anti-Ulcerogenic Effect of Zingiber officinale (Ginger) Root in Rats. Int. J. Curr. Microbiol. App. Sci. 2014, 3, 347–354. Available online: https://api.semanticscholar.org/CorpusID:81914 (accessed on 1 November 2020).
- Zadeh, J.B.; Kor, M.M. Physiological and pharmaceutical effects of Ginger (Zingiber officinale Roscoe) as a valuable medicinal plant. Eur. J. Exp. Biol. 2014, 4, 87–90. [Google Scholar]
- Mahluji, S.; Attari, V.E.; Mobasseri, M.; Payahoo, L.; Ostadrahimi, A.; Golzari, S.E. Effect of ginger (Zingiber officinale) on plasma glucose level, HbA1c and insulin sensitivity in type 2 Diabetic patients. Int. J. Food Sci. Nutr. 2013, 64, 682–686. [Google Scholar] [CrossRef] [PubMed]
- Karna, P.; Chagani, S.; Gundala, S.R.; Rida, P.C.; Asif, G.; Sharma, V.; Gupta, M.V.; Aneja, R. Benefits of whole ginger extract in prostate cancer. Br. J. Nutr. 2012, 107, 473–484. [Google Scholar] [CrossRef]
- Jeong, C.H.; Bode, A.M.; Pugliese, A.; Cho, Y.Y.; Kim, H.G.; Shim, J.H.; Jeon, Y.J.; Li, H.; Jiang, H.; Dong, Z. Gingerol Suppresses Colon Cancer Growth by Targeting Leukotriene A4 Hydrolase. Cancer Res. 2009, 69, 5584–5591. [Google Scholar] [CrossRef] [PubMed]
- Sharma, C.; Ahmed, T.; Sasidharan, S.; Ahmed, M.; Hussain, A. Use of Gemcitabine and Ginger Extract Infusion May Improve the Efficiency of Cervical Cancer Treatment. Afr. J. Biotec. 2009, 8, 7087–7093. [Google Scholar]
- Hegazi, G.A.E.; El-Lamey, T.M. In vitro Production of Some Phenolic Compounds from Ephedra alata Decne. J. Appl. Env. Biol. Sci. 2011, 1, 158–163. Available online: https://www.researchgate.net/publication/285022703 (accessed on 20 April 2023).
- Derbel, S.; Touzard, B.; Triki, M.A.; Chaieb, M. Seed germination responses of the Saharan plant species Ephedra alata ssp. alenda to fungicide seed treatments in the laboratory and the field. Flora 2010, 205, 471–474. [Google Scholar] [CrossRef]
- AL-Qarawi, A.A.; Abd-Allah, E.F.; Abeer, H. Ephedra alata as biologically-based strategy inhibit aflatoxigenic seedborne mold. Afr. J. Microb. Res. 2011, 5, 2297–2303. [Google Scholar]
- El-hilaly, J.; Tahraoui, T.; Israili, Z.H.; Lyoussi, B. Acute hypoglycemic, hypocholesterolemic and hypotriglyceridemic effects of continuous intravenous infusion of a lyophilised aqueous extract of Ajuga Iva L. Schreber whole plant in streptozotocininduced diabetic rats. Pak. J. Pharm. Sci. 2007, 20, 261–268. Available online: https://pubmed.ncbi.nlm.nih.gov/17604246/ (accessed on 1 July 2022).
- El-hilaly, J.; Amarouch, M.Y.; Morel, N.; Lyoussi, B.; Quetin-Leclercq, J. Ajuga iva water extract antihypertensive effect on stroke-prone spontaneously hypertensive rats, vasorelaxant effects ex vivo and in vitro activity of fractions. J. Ethnopharmacol. 2021, 270, 113–791. [Google Scholar] [CrossRef]
- Draghi, F. L’ortiteDioique (Urticadioica L.): Etude bibliographique. Ph.D. Thesis, University of Henri Poincare, Nancy, France, 2005. Available online: https://docnum.univ-lorraine.fr/public/SCDPHA_T_2005_DRAGHI_FRANCINE.pdf (accessed on 1 June 2024).
- Viotti, C.; Albrecht, K.; Amaducci, S.; Bardos, P.; Bertheau, C.; Blaudez, D.; Bothe, L.; Cazaux, D.; Ferrarini, A.; Govilas, J.; et al. Nettle, a Long-Known Fiber Plant with New Perspectives. Materials 2022, 15, 4288. [Google Scholar] [CrossRef] [PubMed]
- Gavamukulya, Y.; Wamunyokoli, F.; El-Shemy, H.A. Annona muricata: Is the natural therapy to most disease conditions including cancer growing in our backyard? A systematic review of its research history and future prospects. Asian Pac. J. Trop Med. 2017, 10, 835–848. [Google Scholar] [CrossRef]
- Rady, I.; Bloch, M.B.; Chamcheu, R.C.; Banang Mbeumi, S.; Anwar, M.R.; Mohamed, H.; Babatunde, A.S.; Kuiate, J.R.; Noubissi, F.K.; El Sayed, K.A.; et al. Anticancer Properties of Graviola (Annona muricata): A Comprehensive Mechanistic Review. Oxid. Med. Cell Longev. 2018, 2018, 1826170. [Google Scholar] [CrossRef]
- Zine, S. Le corossol (Annona muricata L.) et ses propriétés thérapeutiques: État des lieux. Sci. Pharm. 2018, 20–23. Available online: https://dumas.ccsd.cnrs.fr/dumas-01823643 (accessed on 1 July 2021).
- Al-Bayar, A.H. Effect of extraction method of ginger roots on antioxidant activity. Iraqi J. Agric. Sci. 2009, 40, 101–109. Available online: https://www.researchgate.net/publication/303679590 (accessed on 1 January 2023).
- Ali-Rachedi, F.; Meraghni, S.; Touaibia, N.; Sabrina, M. Analyse quantitative des composés phénoliques d’une endémique algérienne Scabiosa atropurpurea. sub. Maritima L. Bull. Société R. Sci. Liège 2018, 87, 13–21. [Google Scholar] [CrossRef]
- Laib, I.; Karit, H.; Bouzerdouna, R.; Kettouche, F.; Barkat, M. Effet de digestion gastro-intestinale in vitro sur les composés phénoliques et l’activité antioxydante d’ail triquètre Allium triquetrum L. J. Appl. Biosci. 2022, 171, 17821–17837. [Google Scholar] [CrossRef]
- Leswara, D.F.; Kurniasih, K.; Sholehah, I.K. The effect of maceration duration on the total flavonoids content of kaempferia parviflora wall. ex baker ethanol extract. Media ILMU Kesehat. 2024, 13, 87–94. [Google Scholar] [CrossRef]
- Sharif, M.F.; Bennett, M.T. The effect of different methods and solvents on the extraction of polyphenols in Ginger (Zingiber officinale). J. Teknol. 2016, 78, 11–12. [Google Scholar] [CrossRef][Green Version]
- Rahath Kubra, I.; Rao, L.J.M.; Kumar, D. Effect of microwave-assisted extraction on the release of polyphenols from ginger (Zingiber officinale). Int. J. Food Sci. Technol. 2013, 48, 1828–1833. [Google Scholar] [CrossRef]
- Belazougui, K.; Mesrouk, S.; Mohammedi, H.; Akcha, S.; Aïnouz, L.; Mecherara-Idjeri, S.F. Phytochemical analysis, mineral composition, Assessment of antioxidant properties and cytotoxic potential of Ephedra alata. subsp. Alenda secondary metabolites. Food Biosci. 2023, 53, 102657. [Google Scholar] [CrossRef]
- Zaater, A.; Serhoud, M.O.; Ben Amor, I.; Zeghoud, S.; Hemmami, A.; Rebiai, A.; Bouras, Y.; Laiche, A.T.; Alsalme, A.; Cornu, D.; et al. Exploring the potential of ephedra alata leaf extract: Phytochemical analysis, antioxidant activity, antibacterial properties, and green synthesis of ZnO nanoparticles for photocatalytic degradation of methylene blue. Front. Chem. 2024, 12, 1367552. [Google Scholar] [CrossRef]
- Muanda, F.N. Identification de Polyphénols, Evaluation de leur Activité Antioxydante et Etude de Leurs Propriétés Biologiques. Ph.D. Thesis, Paul Verlaine University, Metz, France, 2010. Available online: https://hal.univ-lorraine.fr/tel-01752680v1/file/Muanda.Francois.Nsemi.SMZ1011.pdf (accessed on 1 January 2023).
- Do, Q.D.; Angkawijaya, A.E.; Tran-Nguyen, P.L.; Huynh, L.H.; Soetaredjo, F.E.; Ismadji, S.; Ju, Y.H. Effect of extraction solvent on total phenol content, total flavonoid content, and antioxidant activity of Limnophila aromatic. J. Food Drug Anal. 2014, 22, 96–302. [Google Scholar] [CrossRef]
- Bragic, S.; Sofic, E. Chemical composition of various Ephedra species. Bosn. J. Basic Med. Sci. 2015, 15, 21. [Google Scholar] [CrossRef]
- AL-Rimawi, F.; Abu-Lafi, S.; Abbadi, J.; Alamarneh, A. Analysis of phenolic and flavonoids of wild Ephedra alata plant extracts by LC/PDA and LC/MS and their antioxidant activity. Afr. J. Tradit. Complement. Altern. Med. 2017, 14, 130–141. [Google Scholar] [CrossRef]
- Kebili, Z. Contribution à l’étude de Quelques Activités Biologiques des Extraits de Ephedra alata de la région de Ouargla. Master’s Thesis, Kasdi MERBAH University, Ouargla, Algeria, 2016. [Google Scholar]
- Ben Salah, I.; Smaoui, A.; Mahmoudi, H.; Ouerghi, Z. Effet du solvent et de la méthode d’extraction sur les teneurs en composés phénoliques et l’activité antioxydante chez Ephedra alata alenda. IOSR J. Agric. Vet. Sci. (IOSR-JAVS) 2021, 14, 23–30. [Google Scholar]
- Mahmoudi, M.; Boughalleb, F.; Maaloul, S.; Mabrouk, M.; Abdellaoui, R. Phytochemical Screening, Antioxidant Potential, and LC–ESI–MS Profiling of Ephedra alata and Ephedra altissima Seeds Naturally Growing in Tunisia. Appl. Biochem. Biotechnol. 2023, 191, 5903–5915. [Google Scholar] [CrossRef]
- Chouikh, A. Phytochemical profile, antioxidant, analgesic and hypolipidaemic effects of ephedra alata decne female cones extract. Farmacia 2020, 68, 6. [Google Scholar] [CrossRef]
- Bensam, M.; Rechreche, H.; Abdelwahab, A.E.; Abu-Serie, M.M.; Ali, S.M. The role of Algerian ephedra alata ethanolic extract in inhibiting the growth of breast cancer cells by inducing apoptosis in a p53- dependent pathway. Saudi J. Biol. Sci. 2023, 30, 103650. [Google Scholar] [CrossRef]
- Ramanan, M.; Sinha, S.; Sudarshan, K.; Singh Aidhen, I.; Doble, M. Inhibition of the enzymes in the leukotriene and prostaglandin pathways in inflammation by 3-aryl isocoumarins. Eur. J. Med. Chem. 2016, 124, 428–434. [Google Scholar] [CrossRef]
- Sudarshan, K.; Singh Aidhen, I. Convenient Synthesis of 3-Glycosylated Isocoumarins. Eur. J. Org. Chem. 2017, 2017, 34–38. [Google Scholar] [CrossRef]
- Albayati, M.K.; Jawad, A.M.; Khudir, M.H. Evaluation of Zingiber officinaeRosc extract against pathogenic bacteria. Iraqi J. Sci. 2010, 51, 403–409. [Google Scholar]
- Nader, M.I.; Ghanima, K.K.; Ali, S.A.; Azhar, D.A. Antibacterial activity of ginger extracts and its essential oil on some of pathogenic bacteria. Baghdad Sci. J. 2010, 7, 1159–1165. [Google Scholar] [CrossRef]
- Belboukhari, N.; Merzoug, Z.; Cheriti, A.; Sekkoum, K.; Yakoubi, M. Etude de la caractérisation et la composition qualitative des huiles essentielles de six plantes médicinales par spectroscopie IR. Phy. Chem. Bio. Sub. J. 2013, 7, 14–17. Available online: https://www.researchgate.net/publication/260391075 (accessed on 1 February 2023).
- Schulz, H.; Özkan, G.; Baranska, M.; Krüger, H.; Özcan, M. Characterisation of essential oil plants from Turkey by IR and Raman spectroscopy. Vib. Spectrosc. 2005, 39, 249–256. [Google Scholar] [CrossRef]

| Plants | Nettle | Ajuga iva | Graviola | Ginger | Ephedra Alata | |
|---|---|---|---|---|---|---|
| Yield % | Decoction m/v = 0.1 | 7.205 | 15.27 | 14.985 | 25.14 | 15.27 |
| Decoction m/v = 0.067 | 11.805 | 20.995 | 12.02 | 25.305 | 16.455 | |
| Maceration (2-fold) m/v = 0.1 | 12.65 | 6.565 | 3.62 | 23.795 | 18.22 | |
| Maceration (2-fold) m/v = 0.067 | 7.92 | 9.6 | 6.61 | 16.39 | 26.32 | |
| Maceration (3-fold) m/v = 0.067 | 6.765 | 8.755 | 3.06 | 27.465 | 21.07 | |
| Polyphenol Concentration (mg EGA/g DE) | |||||
|---|---|---|---|---|---|
| Extract | Aqueous Extract (Decoction) | Ethanolic Extract (Maceration) | |||
| m/v | 0.1 | 0.067 | 0.1 (2 times) | 0.067 (2 times) | 0.067 (3 times) |
| Ginger | 14.73 ± 0.17 | 31.33 ± 0.58 | 41.10 ± 0.27 | 101.6 ± 0.55 | 103.92 ± 0.08 |
| Ajuga iva | 39.92 ± 0.03 | 36.14 ± 0.16 | 57.94 ± 0.12 | 87.15 ± 0.06 | 88.61 ± 0.14 |
| Graviola | 54.76 ± 0.79 | 51.18 ± 0.16 | 56.48 ± 0.50 | 82.21 ± 0.72 | 124.0 ± 0.27 |
| Ephedra | 237.33 ± 0.13 | 134.95 ± 0.05 | 308.68 ± 0.59 | 137.28 ± 0.14 | 356.76 ± 0.57 |
| Nettle | 50.41 ± 0.08 | 41.10 ± 0.11 | 101.6 ± 0.53 | 133.40 ± 0.42 | 126.41 ± 0.26 |
Disclaimer/Publisher’s Note: The statements, opinions and data contained in all publications are solely those of the individual author(s) and contributor(s) and not of MDPI and/or the editor(s). MDPI and/or the editor(s) disclaim responsibility for any injury to people or property resulting from any ideas, methods, instructions or products referred to in the content. |
© 2025 by the authors. Licensee MDPI, Basel, Switzerland. This article is an open access article distributed under the terms and conditions of the Creative Commons Attribution (CC BY) license (https://creativecommons.org/licenses/by/4.0/).
Share and Cite
Mimi, N.; Madani, L.; Kerrouche, D.; Boucherit, N.; Touzout, N.; Zhang, J.; Amrane, A.; Tahraoui, H. Comparison of Antioxidant and Antibacterial Properties of Five Plants with Anti-Diabetes and Anti-Cancer Potential. Microbiol. Res. 2025, 16, 108. https://doi.org/10.3390/microbiolres16060108
Mimi N, Madani L, Kerrouche D, Boucherit N, Touzout N, Zhang J, Amrane A, Tahraoui H. Comparison of Antioxidant and Antibacterial Properties of Five Plants with Anti-Diabetes and Anti-Cancer Potential. Microbiology Research. 2025; 16(6):108. https://doi.org/10.3390/microbiolres16060108
Chicago/Turabian StyleMimi, Nassiba, Leila Madani, Djamila Kerrouche, Nabila Boucherit, Nabil Touzout, Jie Zhang, Abdeltif Amrane, and Hichem Tahraoui. 2025. "Comparison of Antioxidant and Antibacterial Properties of Five Plants with Anti-Diabetes and Anti-Cancer Potential" Microbiology Research 16, no. 6: 108. https://doi.org/10.3390/microbiolres16060108
APA StyleMimi, N., Madani, L., Kerrouche, D., Boucherit, N., Touzout, N., Zhang, J., Amrane, A., & Tahraoui, H. (2025). Comparison of Antioxidant and Antibacterial Properties of Five Plants with Anti-Diabetes and Anti-Cancer Potential. Microbiology Research, 16(6), 108. https://doi.org/10.3390/microbiolres16060108

